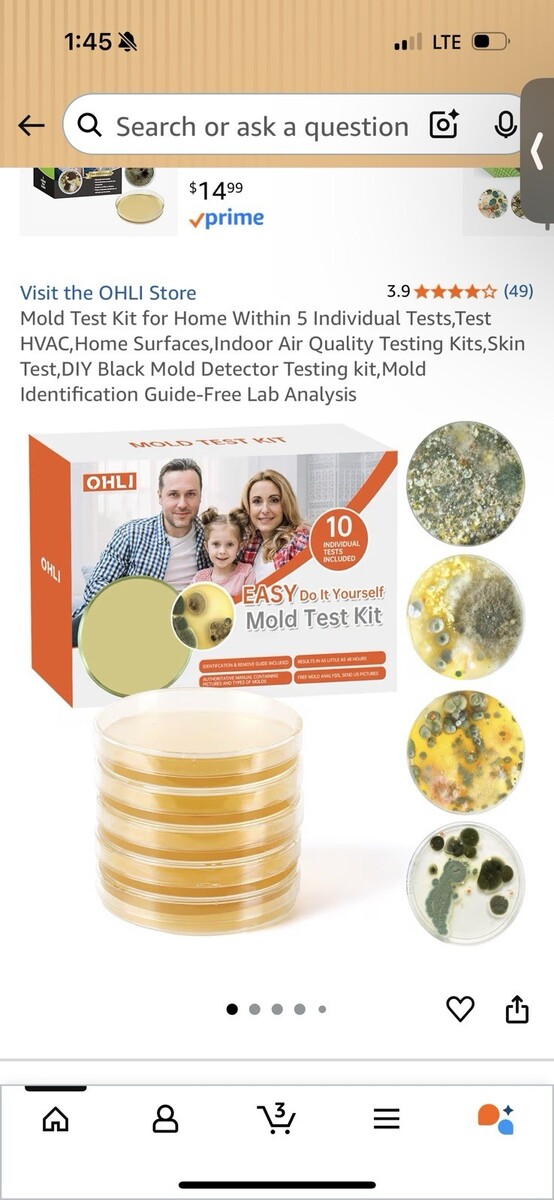
Full-size item image

Rendered at 13:32:03 10/31/25
Mold Test Kit - DIY Home Testing with 5 Indicators NWT
Los buques de
United States

Share & earn! Sign in, share this or any listing, and you’ll get commission when it sells.
Learn more
Las opciones de envío
No hay precio de envío se especifica en ES
Los buques de
United States

Política de oferta
OBO - El vendedor acepta ofertas en este artículo.
Detalles
La política de devoluciones
Protección de compra
Opciones de pago
PayPal accepted
PayPal Credit accepted
Venmo accepted
PayPal, MasterCard, Visa, Discover, and American Express accepted
Maestro accepted
Amazon Pay accepted
Nuvei accepted
Las opciones de envío
No hay precio de envío se especifica en ES
Los buques de
United States

Política de oferta
OBO - El vendedor acepta ofertas en este artículo.
Detalles
La política de devoluciones
Protección de compra
Opciones de pago
PayPal accepted
PayPal Credit accepted
Venmo accepted
PayPal, MasterCard, Visa, Discover, and American Express accepted
Maestro accepted
Amazon Pay accepted
Nuvei accepted
Rasgos del artículo
| Categoría: | |
|---|---|
| cantidad disponible: |
Sólo uno en stock, para muy pronto |
| Condition: |
New |
Detalles del anuncio
| Las políticas del vendedor: | |
|---|---|
| Envío de descuento: |
Pesos de envío de todos los elementos se suman para el ahorro. |
| Publicado en venta: |
October 31 |
| Artículo número: |
1776139769 |
Descripción del Artículo
Ensure your home's safety with the Mold Test Kit. This easy-to-use kit features 5 reliable indicators for quick mold detection. Its vibrant orange design ensures easy identification.
T12
Added to your wish list!

- Mold Test Kit - DIY Home Testing with 5 Indicators NWT
- 1 in stock
- Price negotiable
Get an item reminder
We'll email you a link to your item now and follow up with a single reminder (if you'd like one). That's it! No spam, no hassle.
Already have an account?
Log in and add this item to your wish list.